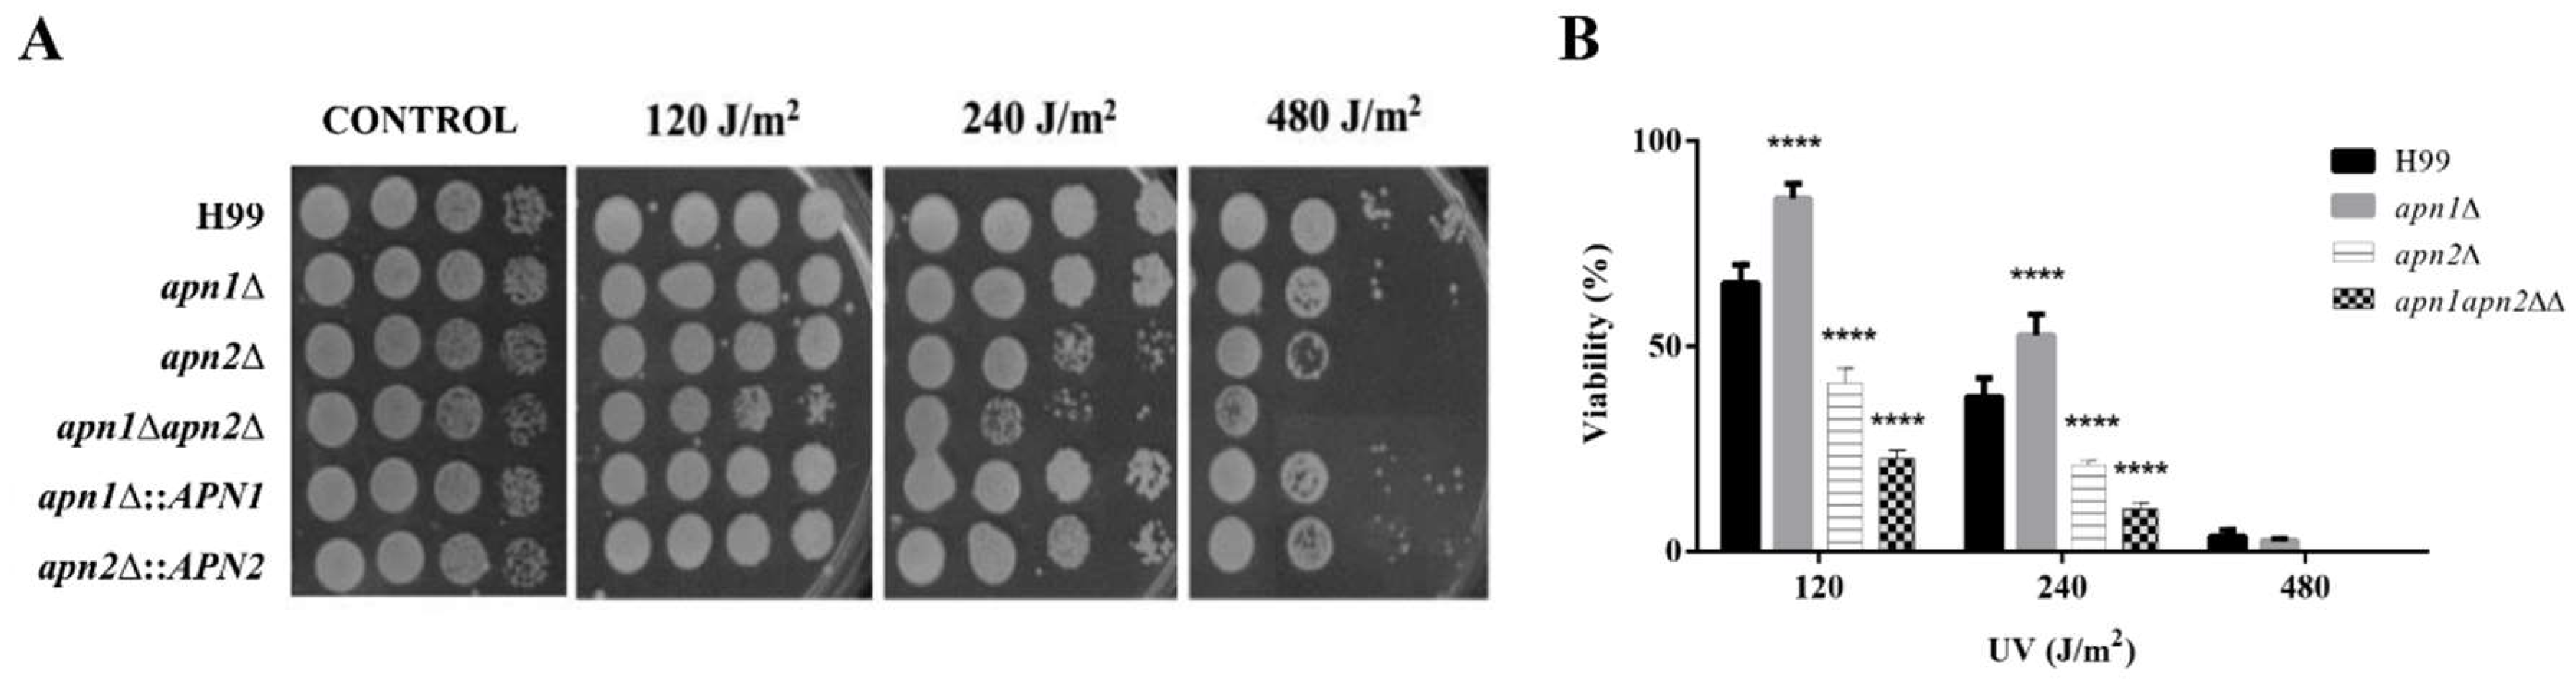
Jof 07 00133 g002 Jof 07 00133 g002

Base Excision Repair AP-Endonucleases-Like Genes Modulate DNA Damage Response and Virulence of the Human Pathogen Cryptococcus neoformans
Abstract
1. Introduction
2. Materials and Methods
2.1. Strain Maintenance
2.2. Phylogenetic Analysis of the Predicted C. neoformans Apn1 and Apn2 Proteins
2.3. Disruption of the APN1- and APN2-Like Genes
2.4. Phenotype Assays
2.5. Growth Curve Analysis
2.6. Evaluation of the Yeast Cells’ Resistance to Genotoxic Stress
2.7. MIC Determination Assays
2.8. Evaluation of Drug Interactions
2.9. In Vitro Phagocytosis Assays
2.9.1. Ethics Statement
2.9.2. Infection of Bone Marrow-Derived Macrophages
2.9.3. Phagocytosis Assay
2.10. Wax Moth Larvae Infection
2.11. Statistical Analyses
3. Results
3.1. Apn2-Like C. neoformans Is an ExoIII/Ape1 Member of the AP Endonucleases Family
3.2. apn1Δ, apn2Δ and apn1Δapn2Δ Mutant Strains Do Not Differ from the Parental Strain Regarding Osmotic or Oxidative Stress Sensitivity
3.3. C. neoformans APN1 and APN2-Like Genes Are Involved in the Repair of DNA Radiation-Induced Lesions
3.4. The Putative Apn2 Endonuclease Is Involved in Processing Alkylation-Induced DNA Damage in C. neoformans
3.5. The Deletion of APN-Like Genes Results in Increased Sensitivity to Zeocin and DNA Fragmentation
3.6. The Inhibition of Recognition of Abasic Sites by Methoxy-Amine Enhances the Fungicidal Effect of Amphotericin B
3.7. The CnApn1 and CnApn2-Like Sequences Are Required for the Production of Melanin
3.8. The Recognition and Correction of Abasic Sites in DNA Is Required for Proper Melanin Production by C. Neoformans
3.9. Predicted C. neoformans Apn1 and Apn2 Proteins Influence Phagocytosis and Fungal Survival within Macrophages In Vitro
3.10. Deletion of APN Genes Provokes Minor Effects in the Wax Moth Larva Model of Infection
4. Discussion
5. Conclusions
Supplementary Materials
Author Contributions
Funding
Institutional Review Board Statement
Informed Consent Statement
Data Availability Statement
Acknowledgments
Conflicts of Interest
References
- Breivik, J.; Gaudernack, G. Resolving the evolutionary paradox of genetic instability: A cost–benefit analysis of DNA repair in changing environments. FEBS Lett. 2004, 563, 7–12. [Google Scholar] [CrossRef]
- Rosenberg, S.M. Mutation for survival. Curr. Opin. Genet. Dev. 1997, 7, 829–834. [Google Scholar] [CrossRef]
- Dion-Côté, A.-M.; Barbash, D.A. Beyond speciation genes: An overview of genome stability in evolution and speciation. Curr. Opin. Genet. Dev. 2017, 47, 17–23. [Google Scholar] [CrossRef]
- Ciccia, A.; Elledge, S.J. The DNA damage response: Making it safe to play with knives. Mol. Cell 2010, 40, 179–204. [Google Scholar] [CrossRef]
- Pichiorri, F.; Ishii, H.; Okumura, H.; Trapasso, F.; Wang, Y.; Huebner, K. Molecular parameters of genome instability: Roles of fragile genes at common fragile sites. J. Cell. Biochem. 2008, 104, 1525–1533. [Google Scholar] [CrossRef] [PubMed]
- Iyama, T.; Wilson, D.M. DNA repair mechanisms in dividing and non-dividing cells. DNA Repair (Amst). 2013, 12, 620–636. [Google Scholar] [CrossRef]
- Friedberg, E.C.; Aguilera, A.; Gellert, M.; Hanawalt, P.C.; Hays, J.B.; Lehmann, A.R.; Lindahl, T.; Lowndes, N.; Sarasin, A.; Wood, R.D. DNA repair: From molecular mechanism to human disease. DNA Repair (Amst). 2006, 5, 986–996. [Google Scholar] [CrossRef] [PubMed]
- Krokan, H.E.; Bjørås, M. Base excision repair. Cold Spring Harb. Perspect. Biol. 2013, 5, a012583. [Google Scholar] [CrossRef]
- DO, Z. Base Excision DNA Repair. Cell. Mol. Life Sci. 2008, 65. [Google Scholar] [CrossRef]
- Schermenhorn, K.M.; Delaney, S.A. Chemical and Kinetic Perspective on Base Excision Repair of DNA. Acc. Chem. Res. 2014, 47. [Google Scholar] [CrossRef]
- Izumi, T.; Hazra, T.K.; Boldogh, I.; Tomkinson, A.E.; Park, M.S.; Ikeda, S.; Mitra, S. Requirement for human AP endonuclease 1 for repair of 3’-blocking damage at DNA single-strand breaks induced by reactive oxygen species. Carcinogenesis 2000, 21, 1329–1334. [Google Scholar] [CrossRef][Green Version]
- Popoff, S.C.; Spira, A.I.; Johnson, A.W.; Demple, B. Yeast structural gene (APN1) for the major apurinic endonuclease: Homology to Escherichia coli endonuclease IV. Proc. Natl. Acad. Sci. 1990, 87, 4193–4197. [Google Scholar] [CrossRef] [PubMed]
- Daley, J.M.; Zakaria, C.; Ramotar, D. The endonuclease IV family of apurinic/apyrimidinic endonucleases. Mutat. Res. Mutat. Res. 2010, 705, 217–227. [Google Scholar] [CrossRef]
- Demple, B.; Herman, T.; Chen, D.S. Cloning and expression of APE, the cDNA encoding the major human apurinic endonuclease: Definition of a family of DNA repair enzymes. Proc. Natl. Acad. Sci. USA 1991, 88, 11450–11454. [Google Scholar] [CrossRef]
- Li, M.; Wilson, D.M. Human apurinic/apyrimidinic endonuclease 1. Antioxid. Redox Signal. 2014, 20, 678–707. [Google Scholar] [CrossRef]
- Fleming, A.M.; Ding, Y.; Burrows, C.J. Oxidative DNA damage is epigenetic by regulating gene transcription via base excision repair. Proc. Natl. Acad. Sci. USA 2017, 114, 2604–2609. [Google Scholar] [CrossRef] [PubMed]
- Evans, A.R.; Limp-Foster, M.; Kelley, M.R. Going APE over ref-1. Mutat. Res. 2000, 461, 83–108. [Google Scholar] [CrossRef]
- Amente, S.; Bertoni, A.; Morano, A.; Lania, L.; Avvedimento, E.V.; Majello, B. LSD1-mediated demethylation of histone H3 lysine 4 triggers Myc-induced transcription. Oncogene 2010, 29, 3691–3702. [Google Scholar] [CrossRef] [PubMed]
- Johnson, R.E.; Torres-Ramos, C.A.; Izumi, T.; Mitra, S.; Prakash, S.; Prakash, L. Identification of APN2, the Saccharomyces cerevisiae homolog of the major human AP endonuclease HAP1, and its role in the repair of abasic sites. Genes Dev. 1998, 12, 3137–3143. [Google Scholar] [CrossRef]
- Unk, I.; Haracska, L.; Johnson, R.E.; Prakash, S.; Prakash, L. Apurinic endonuclease activity of yeast Apn2 protein. J. Biol. Chem. 2000, 275, 22427–22434. [Google Scholar] [CrossRef]
- Bennett, R.A.O. The Saccharomyces cerevisiae ETH1 Gene, an Inducible Homolog of Exonuclease III That Provides Resistance to DNA-Damaging Agents and Limits Spontaneous Mutagenesis. Mol. Cell. Biol. 1999, 19, 1800–1809. [Google Scholar] [CrossRef]
- Legrand, M.; Chan, C.L.; Jauert, P.A.; Kirkpatrick, D.T. Analysis of base excision and nucleotide excision repair in Candida albicans. Microbiology 2008, 154, 2446–2456. [Google Scholar] [CrossRef]
- Ribar, B.; Izumi, T.; Mitra, S. The major role of human AP-endonuclease homolog Apn2 in repair of abasic sites in Schizosaccharomyces pombe. Nucleic Acids Res. 2004, 32, 115. [Google Scholar] [CrossRef] [PubMed]
- Sipiczki, M. Where does fission yeast sit on the tree of life? Genome Biol. 2000, 1, 1–4. [Google Scholar] [CrossRef]
- Merlo, D.; Cuchillo-Ibañez, I.; Parlato, R.; Rammes, G. DNA Damage, Neurodegeneration, and Synaptic Plasticity. Neural Plast. 2016, 2016. [Google Scholar] [CrossRef] [PubMed]
- Penndorf, D.; Witte, O.W.; Kretz, A. DNA plasticity and damage in amyotrophic lateral sclerosis. Neural Regen. Res. 2018, 13, 173. [Google Scholar] [CrossRef]
- Koch, S.C.; Simon, N.; Ebert, C.; Carell, T. Molecular Mechanisms of Xeroderma Pigmentosum (XP) Proteins. Q. Rev. Biophys. 2016, 49. [Google Scholar] [CrossRef]
- Machado, C.R.; Menck, C.F.M. Human DNA repair diseases: From genome instability to cancer. Brazilian J. Genet. 1997, 20, 755–762. [Google Scholar] [CrossRef]
- Gavande, N.S.; VanderVere-Carozza, P.S.; Hinshaw, H.D.; Jalal, S.I.; Sears, C.R.; Pawelczak, K.S.; Turchi, J.J. DNA repair targeted therapy: The past or future of cancer treatment? Pharmacol. Ther. 2016, 160, 65–83. [Google Scholar] [CrossRef] [PubMed]
- Lee, W.; St.Onge, R.P.; Proctor, M.; Flaherty, P.; Jordan, M.I.; Arkin, A.P.; Davis, R.W.; Nislow, C.; Giaever, G.; Friedberg, E.; et al. Genome-Wide Requirements for Resistance to Functionally Distinct DNA-Damaging Agents. PLoS Genet. 2005, 1, e24. [Google Scholar] [CrossRef] [PubMed]
- Zhang, J.; Stevens, M.F.G.; Bradshaw, T.D. Temozolomide: Mechanisms of Action, Repair and Resistance. Curr. Mol. Pharmacol. 2012, 5. [Google Scholar] [CrossRef]
- Liu, L.; Gerson, S.L. Therapeutic impact of methoxyamine: Blocking repair of abasic sites in the base excision repair pathway. Curr. Opin. Investig. Drugs 2004, 5, 623–627. [Google Scholar]
- Scorzoni, L.; de Paula E Silva, A.C.A.; Marcos, C.M.; Assato, P.A.; de Melo, W.C.M.A.; de Oliveira, H.C.; Costa-Orlandi, C.B.; Mendes-Giannini, M.J.S.; Fusco-Almeida, A.M. Antifungal Therapy: New Advances in the Understanding and Treatment of Mycosis. Front. Microbiol. 2017, 8, 36. [Google Scholar] [CrossRef]
- Belenky, P.; Camacho, D.; Collins, J.J. Fungicidal Drugs Induce a Common Oxidative-Damage Cellular Death Pathway. Cell Rep. 2013, 3, 350–358. [Google Scholar] [CrossRef] [PubMed]
- Boiteux, S.; Gellon, L.; Guibourt, N. Repair of 8-oxoguanine in Saccharomyces cerevisiae: Interplay of DNA repair and replication mechanisms. Free Radic. Biol. Med. 2002, 32, 1244–1253. [Google Scholar] [CrossRef]
- Missall, T.A.; Lodge, J.K.; McEwen, J.E. Mechanisms of resistance to oxidative and nitrosative stress: Implications for fungal survival in mammalian hosts. Eukaryot. Cell 2004, 3, 835–846. [Google Scholar] [CrossRef] [PubMed]
- Magditch, D.A.; Liu, T.-B.; Xue, C.; Idnurm, A.; Park, B.; Wannemuehler, K.; Marston, B.; Govender, N.; Pappas, P. DNA Mutations Mediate Microevolution between Host-Adapted Forms of the Pathogenic Fungus Cryptococcus neoformans. PLoS Pathog. 2012, 8, e1002936. [Google Scholar] [CrossRef] [PubMed]
- Liu, O.W.; Chun, C.D.; Chow, E.D.; Chen, C.; Madhani, H.D.; Noble, S.M. Systematic Genetic Analysis of Virulence in the Human Fungal Pathogen Cryptococcus neoformans. Cell 2008, 135, 174–188. [Google Scholar] [CrossRef]
- Brunke, S.; Seider, K.; Fischer, D.; Jacobsen, I.D.; Kasper, L.; Jablonowski, N.; Wartenberg, A.; Bader, O.; Enache-Angoulvant, A.; Schaller, M.; et al. One Small Step for a Yeast—Microevolution within Macrophages Renders Candida glabrata Hypervirulent Due to a Single Point Mutation. PLoS Pathog. 2014, 10, e1004478. [Google Scholar] [CrossRef]
- Esher, S.K.; Zaragoza, O.; Alspaugh, J.A. Cryptococcal pathogenic mechanisms: A dangerous trip from the environment to the brain. Mem. Inst. Oswaldo Cruz 2018, 113. [Google Scholar] [CrossRef] [PubMed]
- Rajasingham, R.; Smith, R.M.; Park, B.J.; Jarvis, J.N.; Govender, N.P.; Chiller, T.M.; Denning, D.W.; Loyse, A.; Boulware, D.R. Global Burden of Disease of HIV-associated Cryptococcal Meningitis: An Updated Analysis. Lancet. Infect. Dis. 2017, 17. [Google Scholar] [CrossRef]
- Kwon-Chung, K.J.; Fraser, J.A.; Doering, T.L.; Wang, Z.; Janbon, G.; Idnurm, A.; Bahn, Y.-S. Cryptococcus neoformans and Cryptococcus gattii, the Etiologic Agents of Cryptococcosis. Cold Spring Harb. Perspect. Med. 2014, 4. [Google Scholar] [CrossRef]
- Kim, M.S.; Kim, S.-Y.; Yoon, J.K.; Lee, Y.-W.; Bahn, Y.-S. An efficient gene-disruption method in Cryptococcus neoformans by double-joint PCR with NAT-split markers. Biochem. Biophys. Res. Commun. 2009, 390, 983–988. [Google Scholar] [CrossRef]
- Price, M.F.; Wilkinson, I.D.; Gentry, L.O. Plate Method for Detection of Phospholipase Activity in Candida Albicans. Sabouraudia 1982, 20. [Google Scholar] [CrossRef]
- Pfaller, M.A.; Rhomberg, P.R.; Messer, S.A.; Castanheira, M. In vitro activity of a Hos2 deacetylase inhibitor, MGCD290, in combination with echinocandins against echinocandin-resistant Candida species. Diagn. Microbiol. Infect. Dis. 2015, 81, 259–263. [Google Scholar] [CrossRef]
- Lutz, M.B.; Kukutsch, N.; Ogilvie, A.L.; Rößner, S.; Koch, F.; Romani, N.; Schuler, G. An advanced culture method for generating large quantities of highly pure dendritic cells from mouse bone marrow. J. Immunol. Methods 1999, 223, 77–92. [Google Scholar] [CrossRef]
- García-Rodas, R.; Casadevall, A.; Rodríguez-Tudela, J.L.; Cuenca-Estrella, M.; Zaragoza, O. Cryptococcus neoformans Capsular Enlargement and Cellular Gigantism during Galleria mellonella Infection. PLoS ONE 2011, 6, e24485. [Google Scholar] [CrossRef] [PubMed]
- Lu, S.; Wang, J.; Chitsaz, F.; Derbyshire, M.K.; Geer, R.C.; Gonzales, N.R.; Gwadz, M.; Hurwitz, D.I.; Marchler, G.H.; Song, J.S.; et al. CDD/SPARCLE: The conserved domain database in 2020. Nucleic Acids Res. 2020, 48, D265–D268. [Google Scholar] [CrossRef] [PubMed]
- Wang, L.; Tsai, C.C. Atrophin proteins: An overview of a new class of nuclear receptor corepressors. Nucl. Recept. Signal. 2008, 6. [Google Scholar] [CrossRef]
- Chankova, S.G.; Dimova, E.; Dimitrova, M.; Bryant, P.E. Induction of DNA double-strand breaks by zeocin in Chlamydomonas reinhardtii and the role of increased DNA double-strand breaks rejoining in the formation of an adaptive response. Radiat. Environ. Biophys. 2007, 46, 409–416. [Google Scholar] [CrossRef] [PubMed]
- Santiago-Tirado, F.H.; Peng, T.; Yang, M.; Hang, H.C.; Doering, T.L. A Single Protein S-acyl Transferase Acts through Diverse Substrates to Determine Cryptococcal Morphology, Stress Tolerance, and Pathogenic Outcome. PLOS Pathog. 2015, 11, e1004908. [Google Scholar] [CrossRef]
- Jung, K.-W.; Yang, D.-H.; Maeng, S.; Lee, K.-T.; So, Y.-S.; Hong, J.; Choi, J.; Byun, H.-J.; Kim, H.; Bang, S.; et al. Systematic functional profiling of transcription factor networks in Cryptococcus neoformans. Nat. Commun. 2015, 6, 6757. [Google Scholar] [CrossRef] [PubMed]
- Osman, F.; Bjørås, M.; Alseth, I.; Morland, I.; McCready, S.; Seeberg, E.; Tsaneva, I. A new Schizosaccharomyces pombe base excision repair mutant, nth1, reveals overlapping pathways for repair of DNA base damage. Mol. Microbiol. 2003, 48, 465–480. [Google Scholar] [CrossRef]
- Swanson, R.L.; Morey, N.J.; Doetsch, P.W.; Jinks-Robertson, S. Overlapping specificities of base excision repair, nucleotide excision repair, recombination, and translesion synthesis pathways for DNA base damage in Saccharomyces cerevisiae. Mol. Cell. Biol. 1999, 19, 2929–2935. [Google Scholar] [CrossRef]
- Legrand, M.; Chan, C.L.; Jauert, P.A.; Kirkpatrick, D.T. Role of DNA Mismatch Repair and Double-Strand Break Repair in Genome Stability and Antifungal Drug Resistance in Candida albicans. Eukaryot. Cell 2007, 6, 2194–2205. [Google Scholar] [CrossRef] [PubMed]
- Schrader, C.E.; Guikema, J.E.; Wu, X.; Stavnezer, J. The roles of APE1, APE2, DNA polymerase β and mismatch repair in creating S region DNA breaks during antibody class switch. Philos. Trans. R. Soc. B Biol. Sci. 2009, 364, 645–652. [Google Scholar] [CrossRef] [PubMed]
- Burkovics, P.; Szukacsov, V.; Unk, I.; Haracska, L. Human Ape2 protein has a 3’-5’ exonuclease activity that acts preferentially on mismatched base pairs. Nucleic Acids Res. 2006, 34, 2508–2515. [Google Scholar] [CrossRef]
- Hossain, M.A.; Lin, Y.; Yan, S. Single-Strand Break End Resection in Genome Integrity: Mechanism and Regulation by APE2. Int. J. Mol. Sci. 2018, 19, 2389. [Google Scholar] [CrossRef] [PubMed]
- Hadi, M.Z.; Ginalski, K.; Nguyen, L.H.; Wilson, D.M. Determinants in nuclease specificity of ape1 and ape2, human homologues of Escherichia coli exonuclease III. J. Mol. Biol. 2002, 316, 853–866. [Google Scholar] [CrossRef]
- Mourad, A.; Perfect, J.R.; Mourad, A.; Perfect, J.R. The war on cryptococcosis: A Review of the antifungal arsenal. Mem. Inst. Oswaldo Cruz 2018, 113. [Google Scholar] [CrossRef]
- Kwon-Chung, K.J.; Chang, Y.C. Aneuploidy and Drug Resistance in Pathogenic Fungi. PLoS Pathog. 2012, 8, e1003022. [Google Scholar] [CrossRef]
- Altamirano, S.; Fang, D.; Simmons, C.; Sridhar, S.; Wu, P.; Sanyal, K.; Kozubowski, L. Fluconazole-Induced Ploidy Change in Cryptococcus neoformans Results from the Uncoupling of Cell Growth and Nuclear Division. mSphere 2017, 2. [Google Scholar] [CrossRef] [PubMed]
- Weiss, G.J.; Gordon, M.S.; Rosen, L.S.; Savvides, P.; Adams, B.J.; Alvarez, D.; Liu, L.; Xu, Y.; Gerson, S.L.; Leigh, B.R. Final results from a phase I study of oral TRC102 (methoxyamine HCl), an inhibitor of base-excision repair, to potentiate the activity of pemetrexed in patients with refractory cancer. J. Clin. Oncol. 2010, 28, 2576. [Google Scholar] [CrossRef]
- Casadevall, A. Determinants of virulence in the pathogenic fungi. Fungal Biol. Rev. 2007, 21, 130. [Google Scholar] [CrossRef]
- Gomez, B.L.; Nosanchuk, J.D. Melanin and Fungi. Curr. Opin. Infect. Dis. 2003, 16. [Google Scholar] [CrossRef] [PubMed]
- Nosanchuk, J.D.; Stark, R.E.; Casadevall, A. Fungal Melanin: What do We Know About Structure? Front. Microbiol. 2015, 6, 1463. [Google Scholar] [CrossRef]
- Gurkan-Cavusoglu, E.; Avadhani, S.; Liu, L.; Kinsella, T.J.; Loparo, K.A. Developing an in silico model of the modulation of base excision repair using methoxyamine for more targeted cancer therapeutics. IET Syst. Biol. 2013, 7, 27–37. [Google Scholar] [CrossRef] [PubMed]
- Sabiiti, W.; May, R.C. Mechanisms of infection by the human fungal pathogen Cryptococcus neoformans. Future Microbiol. 2012, 7, 1297–1313. [Google Scholar] [CrossRef]
- Sabiiti, W.; Robertson, E.; Beale, M.A.; Johnston, S.A.; Brouwer, A.E.; Loyse, A.; Jarvis, J.N.; Gilbert, A.S.; Fisher, M.C.; Harrison, T.S.; et al. Efficient phagocytosis and laccase activity affect the outcome of HIV-associated cryptococcosis. J. Clin. Invest. 2014, 124, 2000–2008. [Google Scholar] [CrossRef]
- Alanio, A.; Desnos-Ollivier, M.; Dromer, F. Dynamics of Cryptococcus neoformans-macrophage interactions reveal that fungal background influences outcome during cryptococcal meningoencephalitis in humans. MBio 2011, 2, e00158-11. [Google Scholar] [CrossRef]
- Tell, G.; Quadrifoglio, F.; Tiribelli, C.; Kelley, M.R. The many functions of APE1/Ref-1: Not only a DNA repair enzyme. Antioxid. Redox Signal. 2009, 11, 601–620. [Google Scholar] [CrossRef] [PubMed]

| Strains | Replicate 1 | Replicate 2 | ||||
|---|---|---|---|---|---|---|
| AmpB (µg/mL) | MX (mg/mL) | Flu (µg/mL) | AmpB (µg/mL) | MX (mg/mL) | Flu (µg/mL) | |
| H99 | 0.25 | 1.25 | 2 | 0.25 | 1.25 | 2 |
| apn1∆ | 0.25 | 1.25 | 2 | 0.25 | 1.25 | 2 |
| apn2∆ | 0.125 | 0.626 | 1 | 0.125 | 0.626 | 1 |
| apn1∆apn2∆ | 0.125 | 0.626 | 1 | 0.125 | 0.626 | 1 |
| apn1∆::APN1 | 0.25 | 1.25 | 2 | 0.25 | 1.25 | 2 |
| apn2∆::APN2 | 0.25 | 1.25 | 2 | 0.25 | 1.25 | 2 |
| Strains | Replicate 1 | Replicate 2 | ||||
|---|---|---|---|---|---|---|
| MICab | MICba | FICI | MICab | MICba | FICI | |
| H99 | 0.0625 | 0.292 | 0.50 | 0.0312 | 0.150 | 0.2498 |
| apn1∆ | 0.0156 | 0.292 | 0.3124 | 0.0625 | 0.078 | 0.3125 |
| apn2∆ | 0.0078 | 0.078 | 0.1874 | 0.0078 | 0.078 | 0.1874 |
| apn1∆apn2∆ | 0.0156 | 0.078 | 0.2498 | 0.0078 | 0.078 | 0.1874 |
Publisher’s Note: MDPI stays neutral with regard to jurisdictional claims in published maps and institutional affiliations. |
© 2021 by the authors. Licensee MDPI, Basel, Switzerland. This article is an open access article distributed under the terms and conditions of the Creative Commons Attribution (CC BY) license (http://creativecommons.org/licenses/by/4.0/).
Share and Cite
Oliveira, R.K.d.M.; Hurtado, F.A.; Gomes, P.H.; Puglia, L.L.; Ferreira, F.F.; Ranjan, K.; Albuquerque, P.; Poças-Fonseca, M.J.; Silva-Pereira, I.; Fernandes, L. Base Excision Repair AP-Endonucleases-Like Genes Modulate DNA Damage Response and Virulence of the Human Pathogen Cryptococcus neoformans. J. Fungi 2021, 7, 133. https://doi.org/10.3390/jof7020133
Oliveira RKdM, Hurtado FA, Gomes PH, Puglia LL, Ferreira FF, Ranjan K, Albuquerque P, Poças-Fonseca MJ, Silva-Pereira I, Fernandes L. Base Excision Repair AP-Endonucleases-Like Genes Modulate DNA Damage Response and Virulence of the Human Pathogen Cryptococcus neoformans. Journal of Fungi. 2021; 7(2):133. https://doi.org/10.3390/jof7020133
Chicago/Turabian StyleOliveira, Rayssa Karla de Medeiros, Fabián Andrés Hurtado, Pedro Henrique Gomes, Luiza Lassi Puglia, Fernanda Fonsêca Ferreira, Kunal Ranjan, Patrícia Albuquerque, Márcio José Poças-Fonseca, Ildinete Silva-Pereira, and Larissa Fernandes. 2021. "Base Excision Repair AP-Endonucleases-Like Genes Modulate DNA Damage Response and Virulence of the Human Pathogen Cryptococcus neoformans" Journal of Fungi 7, no. 2: 133. https://doi.org/10.3390/jof7020133
APA StyleOliveira, R. K. d. M., Hurtado, F. A., Gomes, P. H., Puglia, L. L., Ferreira, F. F., Ranjan, K., Albuquerque, P., Poças-Fonseca, M. J., Silva-Pereira, I., & Fernandes, L. (2021). Base Excision Repair AP-Endonucleases-Like Genes Modulate DNA Damage Response and Virulence of the Human Pathogen Cryptococcus neoformans. Journal of Fungi, 7(2), 133. https://doi.org/10.3390/jof7020133

